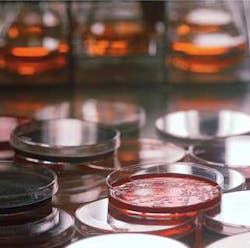
Bacteria Fo Bacteria Fo

It's a bug's life: A look at microbial challenges that have shaped today's practice of dental hygiene
Betsy discussed our current understanding of oral microbial dynamics, and how they have radically evolved during the last few decades. As a result, dental hygienists have a responsibility to stay current on the latest research developments as they practice evidence-based care.
This will enable us to improve professional delivery of periodontal therapy and provide home care recommendations suitable for microbiological control of periopathogens. Betsy’s course provided us a closer look into the world of oral bacterial biofilm, and the impact current research will have on future delivery of dental hygiene care. It was pretty darn entertaining, too!
The session started with a historical look at plaque, and how historical concepts of microbial function have evolved into a broader understanding of how oral biofilm functions. The old adage “It is plaque MASS that overwhelms the body’s ability to control detrimental effects to the oral cavity”, and the dogma that all bacterial deposits had equal potential to induce disease, were dispelled by Betsy. It is no longer one size fits all, or one organism = one disease.
Next, Betsy discussed dietary impact on oral biofilm. As human society shifted from hunting and gathering to farming, changes associated with an increase in grain consumption was reflected in the composition of bacterial plaque biofilm. In medieval times during the Industrial Revolution, another shift in oral bacterial plaque composition occurred, which resulted in less biodiversity and the prevalence of pathogenic bacteria.
Treatment strategies were discussed, and Betsy stressed "biofilm control" versus "bacterial elimination." In other words, shear force and bacterial biofilm control. Treatment strategies and home care recommendations designed to promote a "healthy," diverse oral bacterial population should be implemented.
Thanks Betsy, for your informative and always entertaining presentation!